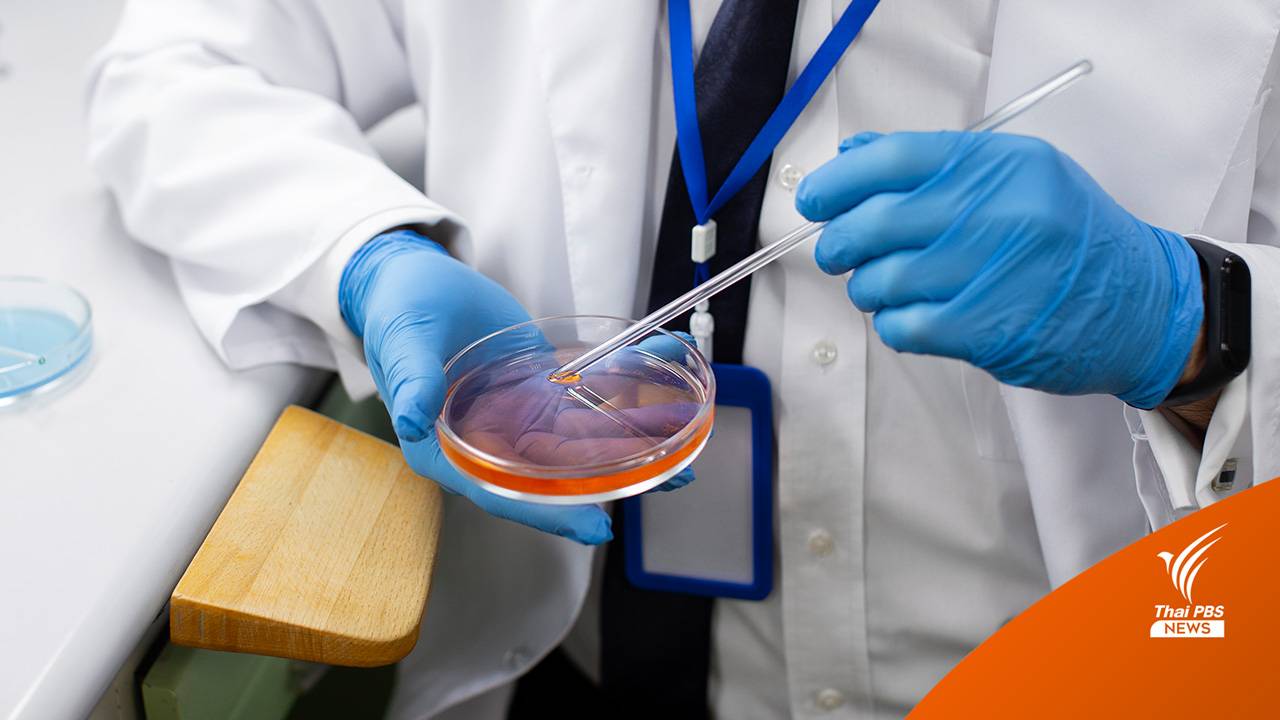

การผลิตเนื้อสัตว์ในห้องแล็บด้วยการเพาะเลี้ยงเซลล์ ได้รับความสนใจและเป็นที่จับตามองไปทั่วโลก แต่คงต้องยอมรับว่านวัตกรรมนี้ยังคงอยู่ในช่วงเริ่มต้นของการพัฒนาและยังไม่พร้อมสำหรับการผลิตเป็นอุตสาหกรรมขนาดใหญ่ เพราะถึงแม้ว่าเนื้อสัตว์ที่ผลิตในห้องปฏิบัติการจะมีข้อดีหลายประการ โดยเฉพาะอย่างยิ่งในการแก้ปัญหาการขาดแคลนอาหารและมีความเป็นมิตรกับสิ่งแวดล้อม แต่ก็มีข้อเสียตรงที่รสชาติไม่เหมือนกับเนื้อสัตว์จากธรรมชาติ จึงอาจทำให้ยังไม่เป็นที่นิยมในหมู่ผู้บริโภค
"เนื้อสัตว์เทียม" ถูกผลิตขึ้นโดยการเพาะเลี้ยงเซลล์สัตว์โดยใช้การผสมผสานระหว่างเทคโนโลยีชีวภาพ วิศวกรรมเนื้อเยื่อ ชีววิทยาระดับโมเลกุล และกระบวนการสังเคราะห์ เทคโนโลยีนี้สามารถสร้างเนื้อสัตว์ที่มีลักษณะคล้ายคลึงกับเนื้อสัตว์จริง แต่อย่างไรก็ตาม เนื้อที่สังเคราะห์ขึ้นยังขาดส่วนประกอบที่เป็นกุญแจสำคัญต่อรสชาติและเนื้อสัมผัส ซึ่งคือ “ไขมัน” นั่นเอง
นักวิทยาศาสตร์พบว่าโมเลกุลไขมันในเนื้อสัตว์ธรรมชาติ ทำให้รสชาติของเนื้ออยู่ในปากยาวนานขึ้น และดูดซับสารอะโรมาติก (Aromatic) ทำให้เนื้อมีรสชาติเข้มข้นขึ้น ด้วยเหตุนี้นักวิทยาศาสตร์จึงได้เพาะเซลล์ไขมันจากหนูและหมูที่มีลักษณะแบนเป็น 2 มิติ จากนั้นจึงนำเซลล์เหล่านั้นมารวมเข้าด้วยกันเป็นเซลล์ที่มีลักษณะเป็น 3 มิติ โดยใช้สารช่วยยึดเกาะ เช่น อัลจิเนต (Alginate) และ mTG
พวกเขาพบว่าไขมันที่ใช้อัลจิเนต (Alginate) เป็นสารช่วยยึดเกาะจะมีความคงตัวและใกล้เคียงกับไขมันจริง แต่ไขมันที่จับกับสารช่วยยึดเกาะ mTG จะมีลักษณะเหมือนไขมันแปรรูปซึ่งคล้ายกับน้ำมันหมูหรือไขมันสัตว์ สิ่งนี้ชี้ให้เห็นว่านักวิทยาศาสตร์สามารถปรับแต่งเนื้อสัมผัสของไขมันที่เพาะเลี้ยงได้อย่างละเอียด เพื่อให้มีลักษณะใกล้เคียงกับเนื้อสัมผัสของไขมันในเนื้อสัตว์จริงมากที่สุด โดยเลือกใช้ประเภทของสารยึดเกาะในปริมาณที่แตกต่างกัน
วิธีการรวมเซลล์ไขมันที่เลี้ยงด้วยสารยึดเกาะนี้ สามารถพัฒนาเป็นการผลิตเนื้อเยื่อไขมันเพาะเลี้ยงในปริมาณมาก หากการทดลองนี้เป็นไปตามที่คาดการณ์ไว้ ความสำเร็จในครั้งนี้จะกลายเป็นหัวใจสำคัญในการพัฒนาเนื้อสัตว์เทียมให้มีรสชาติใกล้เคียงเนื้อสัตว์ธรรมชาติมากขึ้น ซึ่งนักวิทยาศาสตร์ยังคงพัฒนาเทคโนโลยีการผลิตเนื้อสัตว์เพาะเลี้ยงเพื่อนำไปสู่การผลิตเนื้อสัตว์เทียมที่มีรูปลักษณ์ รสชาติ และสัมผัสเหมือนของจริง โดยจะมีบทบาทสำคัญในฐานะอาหารสุขภาพเพื่อเป็นทางเลือกแก่ผู้บริโภคได้ในอนาคต
ที่มาข้อมูล: newatlas, elifesciences, interestingengineering, sciencedaily
“รอบรู้ ดูกระแส ก้าวทันโลก” ไปกับ Thai PBS Sci & Tech